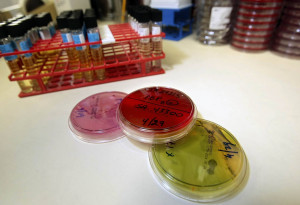
Αντιβιοτικό που βρισκόταν "κάτω από τη μύτη" των επιστημόνων 100 φορές πιο αποτελεσματικό στις ανθεκτικές λοιμώξεις

Δεν επωφελούνται όλοι οι άνθρωποι εξίσου από τα ωμέγα 3 λιπαρά οξέα και οι ερευνητές διαπίστωσαν το γιατί.
Μια νέα μελέτη διαπίστωσε ότι τα οφέλη ενός λιπαρού οξέος γνωστού ως εικοσαπεντανοϊκό οξύ ποικίλλουν σημαντικά από άτομο σε άτομο. Οι ερευνητές αναφέρουν ότι τα αποτελέσματα υπογραμμίζουν τον κρίσιμο ρόλο που διαδραματίζει ο μεταβολισμός του κάθε ατόμου στην προστασία από τις καρδιαγγειακές παθήσεις.
Επιστήμονες στη Φινλανδία διερεύνησαν πώς το εικοσαπεντανοϊκό οξύ (EPA), ένα ωμέγα-3 λιπαρό οξύ που βρίσκεται στο ιχθυέλαιο, επηρεάζει το μεταβολισμό και τα επίπεδα λιπιδίων στο αίμα σε υγιείς ενήλικες.
Ενώ το EPA είναι ήδη αναγνωρισμένο για τη μείωση του καρδιαγγειακού κινδύνου σε άτομα με υψηλή χοληστερόλη ή καρδιακές παθήσεις, τα αποτελέσματά του σε κατά τα άλλα υγιή άτομα δεν έχουν κατανοηθεί καλά. Λίγα ήταν επίσης γνωστά για το πώς το EPA ενσωματώνεται στις λιποπρωτεΐνες, τα σωματίδια που μεταφέρουν τα μόρια λίπους μέσω της κυκλοφορίας του αίματος.
Μεγάλες διακυμάνσεις
Σε αυτή την έρευνα, 38 εθελοντές έλαβαν ασυνήθιστα υψηλές δόσεις συμπληρωμάτων EPA. Λήφθηκαν δείγματα αίματος πριν, κατά τη διάρκεια και μετά τη συμπλήρωση για να παρατηρηθεί πώς ο οργανισμός επεξεργάζεται το λιπαρό οξύ. Τα αποτελέσματα έδειξαν μεγάλες διαφορές μεταξύ των συμμετεχόντων ως προς τον τρόπο με τον οποίο ο οργανισμός τους ανταποκρίθηκε στο EPA.
«Τα δείγματα που ελήφθησαν κατά τη διάρκεια της συμπλήρωσης δείχνουν σαφώς την επίδραση του EPA σε όλους τους συμμετέχοντες. Ωστόσο, όλα τα δείγματα ήταν διαφορετικά μεταξύ τους. Με άλλα λόγια, κάθε άτομο έχει ένα μοναδικό «λιπιδικό αποτύπωμα» , που παρέμεινε αμετάβλητο παρά τη συμπλήρωση με EPA», εξηγεί η καθηγήτρια Katariina Öörni, μία από τις κύριες συγγραφείς της Σχολής Βιολογικών και Περιβαλλοντικών Επιστημών του Πανεπιστημίου του Ελσίνκι και του Ινστιτούτου Ερευνών Wihuri.
Οι ερευνητές επιβεβαίωσαν ότι το EPA απορροφάται αποτελεσματικά, προκαλώντας απότομη αύξηση της συγκέντρωσής του στο αίμα. Ωστόσο, τα επίπεδα μειώθηκαν γρήγορα μόλις σταμάτησε η συμπλήρωση. Οι ισχυρότερες αλλαγές παρατηρήθηκαν σε συμμετέχοντες που ξεκίνησαν με χαμηλότερα αρχικά επίπεδα EPA.
Επιπλέον, το EPA βελτίωσε τα προφίλ των λιπιδίων στο αίμα και μείωσε την τάση των λιποπρωτεϊνών να προσκολλώνται στα τοιχώματα των αρτηριών - ένας σημαντικός παράγοντας στην πρόληψη της αθηροσκλήρωσης.
Βραχυπρόθεσμες επιδράσεις και μελλοντική έρευνα
Επειδή η μελέτη διήρκεσε μόνο για μικρό χρονικό διάστημα, δεν μέτρησε τα μακροπρόθεσμα αποτελέσματα. Ωστόσο, τα ευρήματα αποκαλύπτουν ότι το EPA μπορεί να μεταβάλει τη σύνθεση των λιπιδίων στο αίμα και να επηρεάσει τους πρώιμους μηχανισμούς κινδύνου για αθηροσκλήρωση, ακόμη και σε υγιείς ανθρώπους.
«Τα ευρήματα υπογραμμίζουν τη σημασία του μεταβολισμού στην πρόληψη των καρδιαγγειακών παθήσεων. Οι επιδράσεις του EPA διέφεραν περισσότερο μεταξύ των ατόμων από ό,τι αναμέναμε. Αποδείξαμε επίσης ότι αυτές οι επιδράσεις εξαφανίζονται γρήγορα, κάτι που είναι καλό να γνωρίζουμε σε περίπτωση που το EPA έχει ανεπιθύμητες επιδράσεις», σημειώνει ο διδακτορικός ερευνητής Lauri Äikäs.
Στη συνέχεια, η ομάδα σχεδιάζει να μελετήσει πώς η συμπλήρωση EPA επηρεάζει τα φλεγμονώδη κύτταρα και την παραγωγή λιπιδικών μεσολαβητών που βοηθούν στον έλεγχο της φλεγμονής.
«Είναι ενδιαφέρον να δούμε πώς, για παράδειγμα, οι αλλαγές στη διατροφή επηρεάζουν την ποιότητα των λιποπρωτεϊνών ή το ατομικό λιπιδικό αποτύπωμα», προσθέτει ο Öörni.
Πηγή: Science Daily